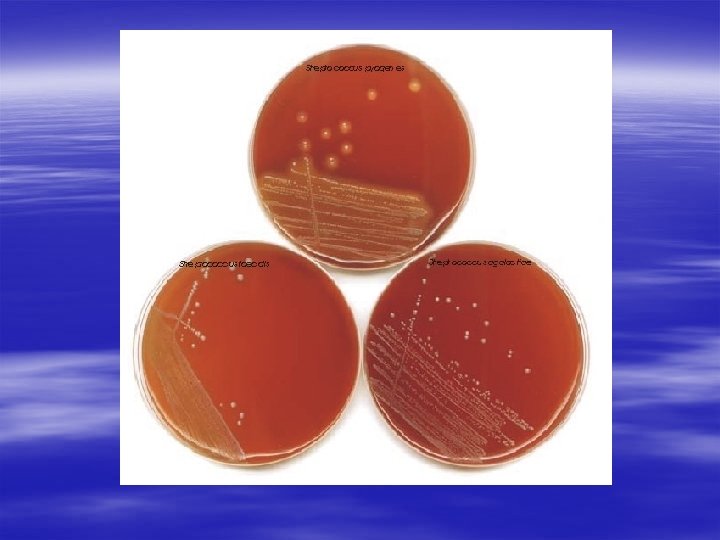
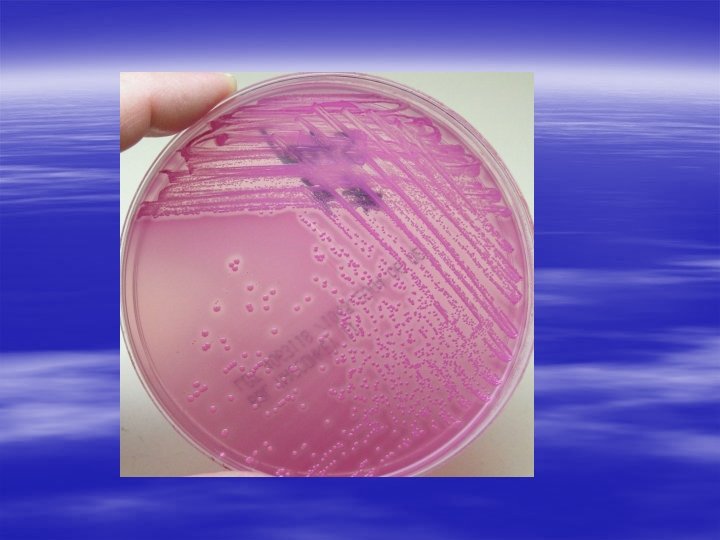

CULTURE MEDIA CULTURE METHODS Bacteria grown on artifical

CULTURE MEDIA & CULTURE METHODS

§ Bacteria grown on artifical cultures for identification & antibiotic testing. § After culture colonies are obtained on solid medium § Colony – macroscopically visible collection of millions of bacteria originating from a single bacterial cell.

History by Louis Pasteur – urine or meat broth • Cooked cut potato by Robert Koch – earliest solid medium Liquid medium – diffuse growth Solid medium – discrete colonies.

AGAR § § § Used for preparing solid medium Obtained from seaweeds. No nutritive value Not affected by the growth of the bacteria. Melts at 98 o. C & sets at 42 o. C 2% agar is employed in solid medium

Types of culture media I. II. Based on consistency a) solid medium b) liquid medium c) semi solid medium Based on ingredients a) simple medium b) complex medium c) synthetic or defined medium d) Special media

Special media – – – – Enriched media Enrichment media Selective media Indicator media Differential media Sugar media Transport media Media for biochemical reactions III. Based on Oxygen requirement - Aerobic media - Anaerobic media

Solid media – contains 2% agar § Colony morphology, pigmentation, hemolysis can be appreciated. § eg: Nutrient agar, Blood agar Liquid media – no agar. § For inoculum preparation § Blood culture § eg: Nutrient broth Semi solid medium – 0. 5% agar. § eg: Motility medium


Simple media / basal media - eg: Nutrient Broth, Nutrient Agar - NB consists of peptone, meat extract, Na. Cl, NB + 2% agar = Nutrient agar

Complex media § Media other than basal media. § They have added ingredients. § Provide special nutrients Synthetic or defined media § Media prepared from pure chemical substances and its exact composition is known § eg: peptone water – 1% peptone + 0. 5% Na. Cl in water

Enriched media § Substances like blood, serum, egg are added to the basal medium. § Used to grow bacteria that are exacting in their nutritional needs. § eg: Blood agar, Chocolate agar BA—haematin X factor CA-lysed BA (80 o C) X +V factor(NAD)

Blood agar Chocolate agar

Enrichment media § Liquid media used to isolate pathogens from a mixed culture. § Media is incorporated with inhibitory substances to suppress the unwanted organism. § eg: – Selenite F Broth – for the isolation of Salmonella, Shigella – Alkaline Peptone Water – for Vibrio cholerae

Selective media § The inhibitory substance is added to a solid media. eg: § Mac Conkey’s medium for gram negative bacteria § TCBS – for V. cholerae § LJ medium – M. tuberculosis § Wilson and Blair medium – S. typhi § Potassium tellurite medium – Diphtheria bacilli

Mac Conkey’s medium TCBS

Potassium Tellurite media LJ media

INDICATOR MEDIA § contain an indicator which changes its colour when a bacterium grows in them. eg: • Mac. Conkey’s medium • Christensen’s urease medium

Urease medium

Differential media/ selective § A media which has substances incorporated in it enabling it to distinguish between bacteria. § eg: Mac Conkey’s medium – Peptone – Lactose – Agar – Neutral red – Taurocholate (bile salt) § Distinguish between lactose fermenters & non lactose fermenters.

§ Lactose fermenters – Pink colonies § Non lactose fermenters – colourless colonies

Sugar media § Media containing any fermentable substance. § eg: glucose, arabinose, lactose, starch etc. § Media consists of 1% of the sugar in peptone water. § Contain a small tube (Durham’s tube) for the detection of gas by the bacteria.


Transport media § used for transporting the samples. § Delicate organisms may not survive the time taken for transporting the specimen without a transport media. § eg: – Stuart’s medium – non nutrient soft agar gel containing a reducing agent – Buffered glycerol saline – enteric bacilli

Anaerobic media § These media are used to grow anaerobic organisms. § Eg: Robertson’s cooked meat medium, Thioglycolate medium.

BIOCHEMICAL TEST & REACTIONS § They provide additional information for the identification of the bacterium. § The tests include: – Oxidase test – Triple sugar iron agar (TSI) – Indole test – Citrate utilization – Urease test

OXIDASE TEST § Detects the presence of an enzyme “oxidase” produced by certain bacteria which will reduce the dye – tetramethyl-p-phenylene diamine dihydrochloride. § Positive test is indicated by the development of a purple colour. § Oxidase positive – Pseudomonas, Vibrio, Neisseriae § Oxidase negative – Salmonella, Shigella


TRIPLE SUGAR IRON AGAR (TSI) § It is a composite media used to study different properties of a bacterium – sugar fermentation, gas production and H 2 S production. § In addition to peptone, yeast extract & agar, it contains 3 sugars – Glucose, Lactose, Sucrose. § The Iron salt – Ferric citrate indicates H 2 S production. § Phenol red is the indicator. § It is an orange red medium with a slant and a butt. § p. H of the medium – 7. 4

TSI REACTIONS: § § § § Yellow – Acid Pink - Alkaline Yellow slant / Yellow butt (A/A) – Lactose fermenters. Pink slant / Yellow butt (K/A) – Non lactose fermenters. Pink slant / no colour change (K/K) – Non fermenters Black colour – H 2 S production. Gas bubbles or crack in the medium – gas production. LF – E. coli, Klebsiella NLF – Salmonella, Shigella H 2 S - Proteus


INDOLE TEST § Used to detect indole production by the organism. § They produce indole from tryptophan present in peptone water. § After overnight incubation, a few drops of indole reagent (Kovac’s reagent) is added. § Positive test is indicated by a pink ring. – Positive indole test – pink ring – Negative indole test - yellow ring § Indole positive – E. coli § Indole negative – Klebsiella, Salmonella.


CITRATE UTILIZATION § Done in Simmon’s Citrate medium. § To detect the ability of certain bacteria to utilize citrate as the sole source of carbon. § Contains Sodium citrate and bromothymol blue as the indicator. § If citrate is utilized, alkali is produced which turns the medium to blue. – Citrate positive – blue colour – Citrate negative – green colour § Positive – Klebsiella § Negative – E. coli


UREASE TEST § Done in Christensen’s urease medium. § This test is used to detect organisms that produce urease. § Urease produced by the organisms split urea into ammonia and CO 2. – Urease positive – pink colour – Urease negative – yellow colour § Positive – Proteus, Klebsiella § Negative – E. coli, Salmonella


CULTURE METHODS § Culture methods employed depend on the purpose for which they are intended. § The indications for culture are: – To isolate bacteria in pure cultures. – To demonstrate their properties. – To obtain sufficient growth for the preparation of antigens and for other tests. – For bacteriophage & bacteriocin susceptibility. – To determine sensitivity to antibiotics. – To estimate viable counts. – Maintain stock cultures.

Culture methods include: § Streak culture § Lawn culture § Stroke culture § Stab culture § Pour plate method § Liquid culture § Anaerobic culture methods

STREAK CULTURE § Used for the isolation of bacteria in pure culture from clinical specimens. § Platinum wire or Nichrome wire is used. § One loopful of the specimen is transferred onto the surface of a well dried plate. § Spread over a small area at the periphery. § The inoculum is then distributed thinly over the plate by streaking it with a loop in a series of parallel lines in different segments of the plate. § On incubation, separated colonies are obtained over the last series of streaks.

LAWN CULTURE § Provides a uniform surface growth of the bacterium. § Uses – For bacteriophage typing. – Antibiotic sensitivity testing. – In the preparation of bacterial antigens and vaccines. § Lawn cultures are prepared by flooding the surface of the plate with a liquid suspension of the bacterium.

Antibiotic sensitivity testing

STROKE CULTURE § Stroke culture is made in tubes containing agar slope / slant. § Uses – Provide a pure growth of bacterium for slide agglutination and other diagnostic tests.

STAB CULTURE § Prepared by puncturing a suitable medium – gelatin or glucose agar with a long, straight, charged wire. § Uses – Demonstration of gelatin liquefaction. – Oxygen requirements of the bacterium under study. – Maintenance of stoke cultures.

Gelatin liquefaction Oxidation – Fermentation medium

POUR PLATE CULTURE § Agar medium is melted (15 ml) and cooled to 45 o. C. § 1 ml of the inoculum is added to the molten agar. § Mix well and pour to a sterile petri dish. § Allow it to set. § Incubate at 37 o. C, colonies will be distributed throughout the depth of the medium. § Uses – Gives an estimate of the viable bacterial count in a suspension. – For the quantitative urine cultures.

LIQUID CULTURES § Liquid cultures are inoculated by touching with a charged loop or by adding the inoculum with pipettes or syringes. § Uses – Blood culture – Sterility tests – Continuous culture methods § Disadvantage – It does not provide a pure culture from mixed inocula.

Blood culture bottles

ANAEROBIC CULTURE METHODS § Anaerobic bacteria differ in their requirement and sensitivity to oxygen. § Cl. tetani is a strict anaerobe – grows at an oxygen tension < 2 mm Hg. Methods: – Production of vacuum – Displacement of oxygen with other gases – Chemical method – Biological method – Reduction of medium

Production of vacuum: § Incubate the cultures in a vacuum desiccator. Displacement of oxygen with other gases § Displacement of oxygen with hydrogen, nitrogen, helium or CO 2. § Eg: Candle jar


Chemical method § Alkaline pyrogallol absorbs oxygen. Mc. Intosh – Fildes’ anaerobic jar § Consists of a metal jar or glass jar with a metal lid which can be clamped air tight. § The lid has 2 tubes – gas inlet and gas outlet § The lid has two terminals – connected to electrical supply. § Under the lid – small grooved porcelain spool, wrapped with a layer of palladinised asbestos.


Working: § Inoculated plates are placed inside the jar and the lid clamped air tight. § The outlet tube is connected to a vacuum pump and the air inside is evacuated. § The outlet tap is then closed and the inlet tube is connected to a hydrogen supply. § After the jar is filled with hydrogen, the electric terminals are connected to a current supply, so that the palladinised asbestos is heated. § Act as a catalyst for the combination of hydrogen with residual oxygen.

Gaspak § Commercially available disposable envelope. § Contains chemicals which generate H 2 and CO 2 on addition of water. § Cold catalyst – in the envelope § Indicator is used – reduced methylene blue. – Colourless – anaerobically – Blue colour – on exposure to oxygen


Biological method § Absorption of oxygen by incubation with aerobic bacteria, germinating seeds or chopped vegetables. Reduction of oxygen § By using reducing agents – 1% glucose, 0. 1% Thioglycolate

THANK YOU
- Slides: 60